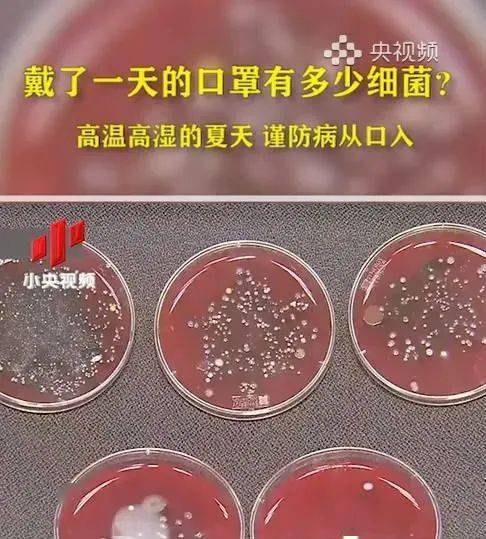
戴了一天的口罩里有多少细菌?检测结果竟然是

细菌图片吓死人 口罩

戴了一天的口罩里有多少细菌?检测结果竟然是
图片尺寸486x539
精选|尘大侠电动防病毒口罩,五层过滤网,少量库存|细菌_新浪科技_新浪
图片尺寸1399x932
疫情防控的核酸检测指南|口罩|病毒|细菌|酒精_网易订阅
图片尺寸648x401
鹰嘴龙 一次性口罩独立包装一次性口罩防尘成人挂耳式防细菌飞沫 10个
图片尺寸350x350
歪果仁不爱戴口罩的理由,跪了.|口腔|牙菌斑|细菌|益生菌_网易订阅
图片尺寸660x346
口罩佩戴超4小时会变细菌培养皿?
图片尺寸1080x608
9!全家防护大礼包,100片口罩 500ml免洗手消毒凝胶,速抢!_细菌
图片尺寸1080x720
儿童n95级别防护口罩防病毒病菌小孩专用一次性外科洁依诺儿童n95 洁
图片尺寸790x1238
嘉信美:佩戴口罩常见的4个错误,看看你有没有犯?_细菌
图片尺寸448x448
人多的地方多细菌也多今天你出门戴口罩了吗
图片尺寸620x400
一个令人难堪的事实:戴了口罩才发现自己嘴有多臭|漱口水|口腔|细菌
图片尺寸650x810
口罩防护病菌专用一次性囗罩带呼吸阀防尘防飞沫独立包装kn95白色带
图片尺寸790x996
尤其是指甲缝,指甲缝里可藏的细菌 超过30亿只!
图片尺寸640x695
戴上了口罩却忽略了病虫口入另一个原因筷子
图片尺寸660x373
你会正确洗手吗?|细菌_新浪财经_新浪网
图片尺寸640x491
超级细菌你别怕我来为你保驾护航
图片尺寸625x736
原创伍连德百年前拯救东北于鼠疫之中的抗疫英雄中国口罩的发明者
图片尺寸1024x696
你会正确洗手吗?|细菌_新浪财经_新浪网
图片尺寸640x640
经常戴一次性口罩要留意,我也是今天才清楚,叮嘱家人都学学|圆圆|细菌
图片尺寸660x441
除了洗手,戴口罩必须注意4点|细菌|洗手液|酒精|肥皂_网易订阅
图片尺寸640x491